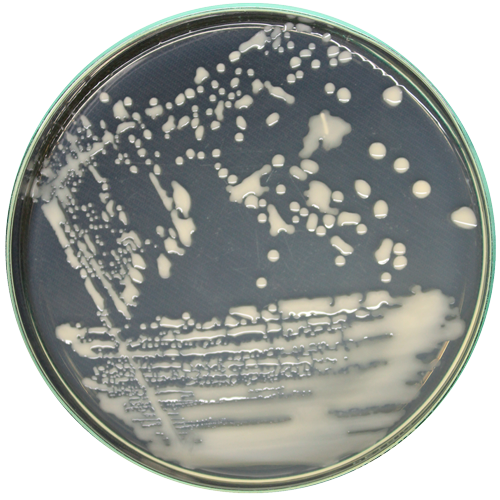

$97.298 más I.V.A.
RGM 3218
Categoría:
Género:
Rhodococcus
Especie:
sp.
Cepa tipo:
No
Código de otra colección:
MAU-361
Fecha de aislamiento:
2021-02-15
País de origen:
Chile
Historial de deposito:
Instituto de Investigaciones Agropecuarias (INIA)
Sustrato de origen:
Suelo
Acceso GenBank:
Temperatura óptima de crecimiento:
25º
Regiónalizas secuenciada:
ARNr 16S
Medio de cultivo:
Agar nutriente
Nivel de riesgo:
Restricciones de distribución:
Restricción de distribución sólo a Región del Maule (restricción expira en 2026)
Información adicional:
Fecha de subida al catálogo:
Secuencias nucleotídicas:
Otros comentarios: